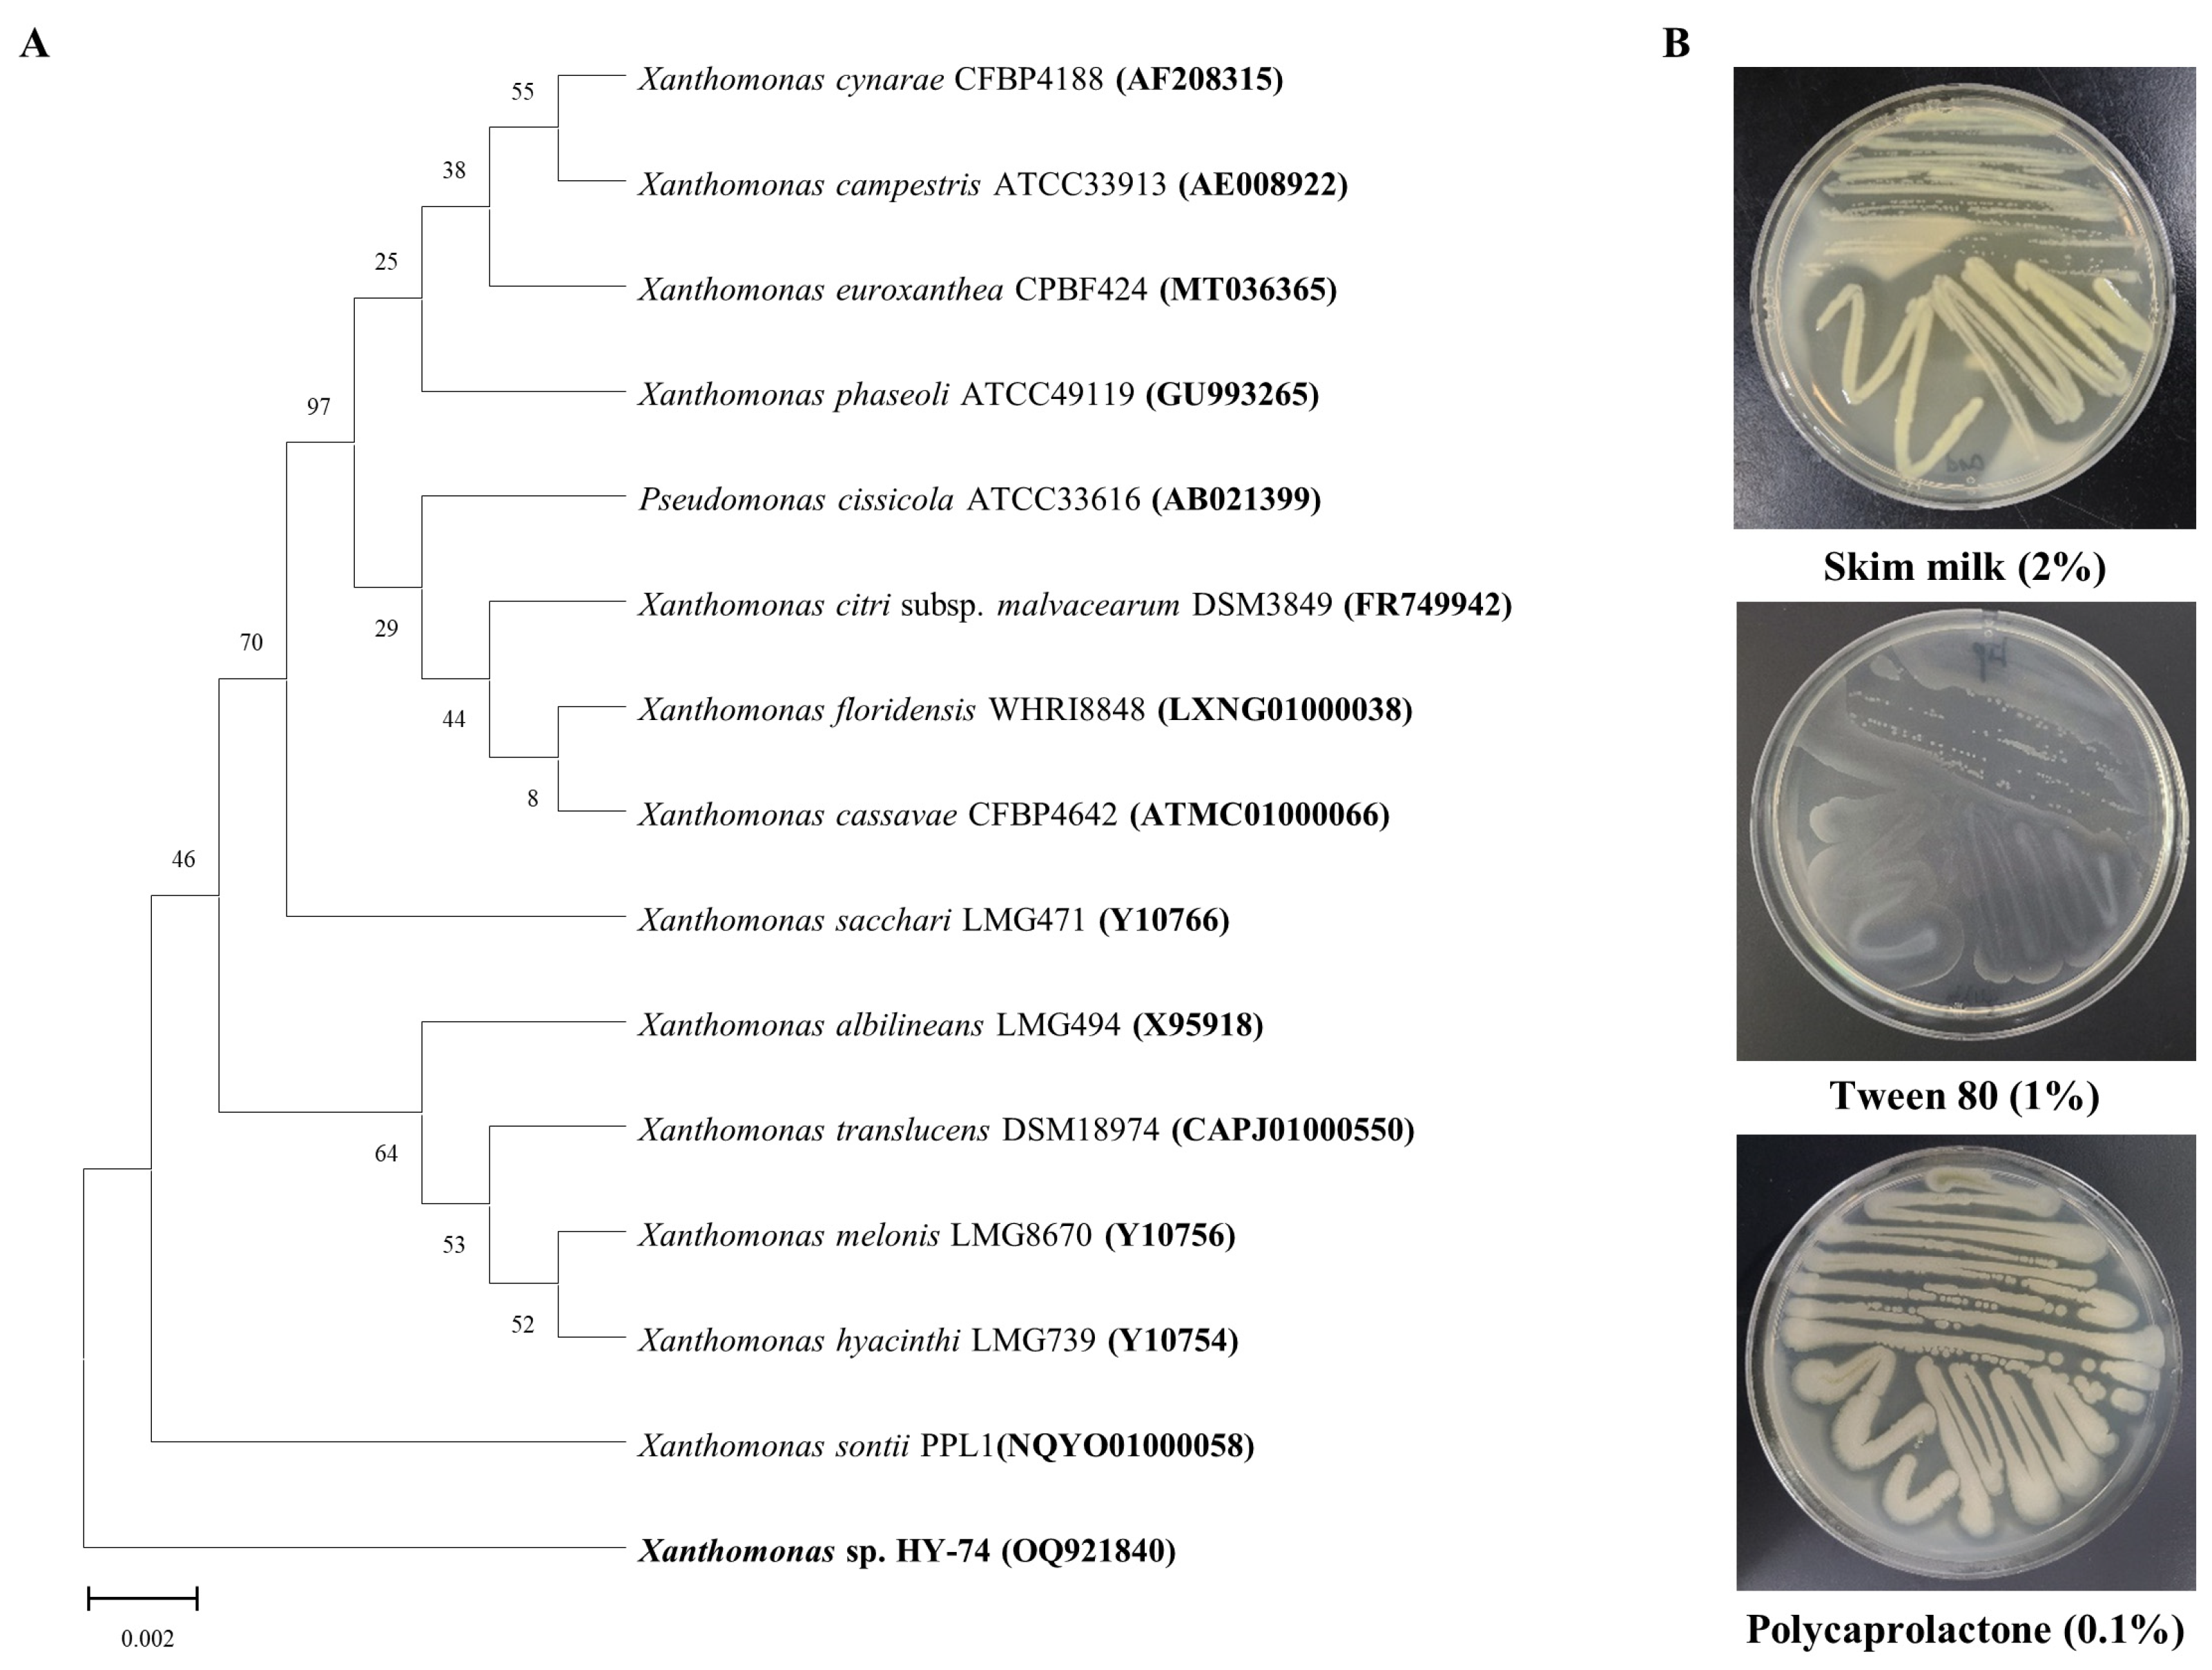
Polymers 15 03546 g001

Biodegradation Potential of Polyethylene Terephthalate by the Two Insect Gut Symbionts Xanthomonas sp. HY-74 and Bacillus sp. HY-75
Abstract
:1. Introduction
2. Materials and Methods
2.1. Plastic Materials
2.2. Screening, Isolation, and Identification of PET Degrading Bacteria
2.3. Sole Nutrition Source Assay
2.4. Degradation of PET Film
2.5. PET Powder Degradation Assay
2.6. Statistical Analysis
3. Results
3.1. Isolation and Identification of PET Degrading Strain
3.2. Sole Nutrition Source Assay
3.3. PET Film Degradation
3.4. Degradation of PET Powder
4. Discussion
5. Conclusions
Supplementary Materials
Author Contributions
Funding
Institutional Review Board Statement
Data Availability Statement
Conflicts of Interest
References
- OECD. Plastic Pollution Is Growing Relentlessly as Waste Management and Recycling Fall Short, Says OECD. 2022. Available online: https://www.oecd.org/environment/plastic-pollution-is-growing-relentlessly-as-waste-management-and-recycling-fall-short.htm (accessed on 22 December 2022).
- Geyer, R.; Jambeck, J.R.; Law, K.L. Production, use, and fate of all plastics ever made. Sci. Adv. 2017, 3, e1700782. [Google Scholar] [CrossRef]
- Andrady, A.L.; Neal, M.A. Applications and societal benefits of plastics. Philos. Trans. R. Soc. B Biol. Sci. 2009, 364, 1977–1984. [Google Scholar] [CrossRef]
- Yoshida, S.; Hiraga, K.; Takehana, T.; Taniguchi, I.; Yamaji, H.; Maeda, Y.; Toyohara, K.; Miyamoto, K.; Kimura, Y.; Oda, K. A bacterium that degrades and assimilates poly (ethylene terephthalate). Science 2016, 351, 1196–1199. [Google Scholar] [CrossRef]
- Maheswaran, B.; Al-Ansari, M.; Al-Humaid, L.; Raj, J.S.; Kim, W.; Karmegam, N.; Rafi, K.M. In vivo degradation of polyethylene terephthalate using microbial isolates from plastic polluted environment. Chemosphere 2023, 310, 136757. [Google Scholar] [CrossRef]
- Ribitsch, D.; Heumann, S.; Trotscha, E.; Herrero Acero, E.; Greimel, K.; Leber, R.; Birner-Gruenberger, R.; Deller, S.; Eiteljoerg, I.; Remler, P.; et al. Hydrolysis of polyethyleneterephthalate by p-nitrobenzylesterase from Bacillus subtilis. Biotechnol. Prog. 2011, 27, 951–960. [Google Scholar] [CrossRef]
- Jadaun, J.S.; Bansal, S.; Sonthalia, A.; Rai, A.K.; Singh, S.P. Biodegradation of plastics for sustainable environment. Bioresour. Technol. 2022, 347, 126697. [Google Scholar] [CrossRef]
- Roberts, C.; Edwards, S.; Vague, M.; León-Zayas, R.; Scheffer, H.; Chan, G.; Swartz, N.A.; Mellies, J.L. Environmental consortium containing Pseudomonas and Bacillus species synergistically degrade polyethylene terephthalate plastic. mSphere 2020, 5, e01151-20. [Google Scholar] [CrossRef]
- Bollinger, A.; Thies, S.; Knieps-Grünhagen, E.; Gertzen, C.; Kobus, S.; Höppner, A.; Ferrer, M.; Gohlke, H.; Smits, S.H.; Jaeger, K.E. A novel polyester hydrolase from the marine bacterium Pseudomonas aestusnigri–structural and functional insights. Front. Microbiol. 2020, 11, 114. [Google Scholar] [CrossRef]
- Vague, M.; Chan, G.; Roberts, C.; Swartz, N.A.; Mellies, J.L. Pseudomonas isolates degrade and form biofilms on polyethylene terephthalate (PET) plastic. bioRxiv 2019, 647321. [Google Scholar] [CrossRef]
- Kawai, F.; Kawabata, T.; Oda, M.; Murase, Y. Discovery of a new bacterial PET hydrolase and synthetic PET degradation by combined culture of Ideonella sakaiensis and a hydrolytic bacterium. Sci. Rep. 2019, 9, 13845. [Google Scholar]
- Li, J.; Gu, J.D.; Pan, L. Transformation of dimethyl phthalate, dimethyl isophthalate and dimethyl terephthalate by Rhodococcus rubber Sa and modeling the processes using the modified Gompertz model. Int. Biodeterior. Biodegrad. 2005, 55, 223–232. [Google Scholar] [CrossRef]
- Bowditch, T.G. Penetration of polyvinyl chloride and polypropylene packaging films by Ephestia cautella (lepidoptera: Pyralidae) and Plodia interpunctella (Lepidoptera: Pyralidae) Larvae, and Tribolium confusum (Coleoptera: Tenebrionidae) Adults. J. Econ. Entomol. 1997, 90, 1028–1031. [Google Scholar] [CrossRef]
- Yang, Y.; Yang, J.; Wu, W.M.; Zhao, J.; Song, Y.; Gao, L.; Yang, R.; Jiang, L. Biodegradation and mineralization of polystyrene by plastic-eating mealworms: Part 1. Chemical and physical characterization and isotopic tests. Environ. Sci. Technol. 2015, 49, 12080–12086. [Google Scholar] [CrossRef] [PubMed]
- Yang, Y.; Chen, J.; Wu, W.M.; Zhao, J.; Yang, J. Complete genome sequence of Bacillus sp. YP1, a polyethylene-degrading bacterium from waxworm’s gut. J. Biotechnol. 2015, 200, 77–78. [Google Scholar] [CrossRef]
- Nyamjav, I.; Jang, Y.; Park, N.; Lee, Y.E.; Lee, S. Physicochemical and structural evidence that Bacillus cereus isolated from the gut of waxworms (Galleria mellonella larvae) biodegrades polypropylene efficiently in vitro. J. Polym. Environ. 2023, 1–14. [Google Scholar] [CrossRef]
- Bhagobaty, R.K.; Joshi, S.R. Enzymatic activity of fungi endophytic on five medicinal plant species of the pristine sacred forests of Meghalaya, India. Biotechnol. Bioprocess. 2012, 17, 33–40. [Google Scholar] [CrossRef]
- Thompson, J.D.; Gibson, T.J.; Plewniak, F.; Jeanmougin, F.; Higgins, D.G. The CLUSTAL_X windows interface: Flexible strategies for multiple sequence alignment aided by quality analysis tools. Nucl. Acids Res. 1997, 25, 4876–4882. [Google Scholar] [CrossRef]
- Jang, S.; Kikuchi, Y. Impact of the insect gut microbiota on ecology, evolution, and industry. Curr. Opin. Insect Sci. 2020, 41, 33–39. [Google Scholar] [CrossRef]
- Sanchez-Hernandez, J.C. A toxicological perspective of plastic biodegradation by insect larvae. Comp. Biochem. Physiol. C Toxicol. Pharmacol. 2021, 248, 109117. [Google Scholar] [CrossRef]
- Lou, Y.; Li, Y.; Lu, B.; Liu, Q.; Yang, S.S.; Liu, B.; Ren, N.; Wu, W.M.; Xing, D. Response of the yellow mealworm (Tenebrio molitor) gut microbiome to diet shifts during polystyrene and polyethylene biodegradation. J. Hazard. Mater. 2021, 416, 126222. [Google Scholar] [CrossRef]
- Peng, B.Y.; Sun, Y.; Wu, Z.; Chen, J.; Shen, Z.; Zhou, X.; Wu, W.M.; Zhang, Y. Biodegradation of polystyrene and low-density polyethylene by Zophobas atratus larvae: Fragmentation into microplastics, gut microbiota shift, and microbial functional enzymes. J. Clean. Prod. 2022, 367, 132987. [Google Scholar] [CrossRef]
- Latour, S.; Noël, G.; Serteyn, L.; Sare, A.R.; Massart, S.; Delvigne, F.; Francis, F. Multi-omics approach reveals new insights into the gut microbiome of Galleria mellonella (Lepidoptera: Pyralidae) exposed to polyethylene diet. bioRxiv 2021, 6. [Google Scholar] [CrossRef]
- Bulak, P.; Proc, K.; Pytlak, A.; Puszka, A.; Gawdzik, B.; Bieganowski, A. Biodegradation of different types of plastics by Tenebrio molitor insect. Polymers 2021, 13, 3508. [Google Scholar] [CrossRef] [PubMed]
- Peng, B.Y.; Chen, Z.; Chen, J.; Yu, H.; Zhou, X.; Criddle, C.S.; Wu, W.M.; Zhang, Y. Biodegradation of Polyvinyl Chloride (PVC) in Tenebrio molitor (Coleoptera: Tenebrionidae) larvae. Environ. Int. 2020, 145, 106106. [Google Scholar] [CrossRef] [PubMed]
- Zhang, Z.; Peng, H.; Yang, D.; Zhang, G.; Zhang, J.; Ju, F. Polyvinyl chloride degradation by a bacterium isolated from the gut of insect larvae. Nat. Commun. 2022, 13, 5360. [Google Scholar] [CrossRef]
- Kim, J.H.; Choi, S.H.; Park, M.G.; Park, D.H.; Son, K.H.; Park, H.Y. Biodegradation of polyurethane by Japanese carpenter bee gut-associated symbionts Xanthomonas sp. HY-71, and its potential application on bioconversion. Environ. Technol. Innov. 2022, 28, 102822. [Google Scholar] [CrossRef]
- Kim, J.H.; Choi, S.H.; Park, M.G.; Park, D.H.; Son, K.H.; Park, H.Y. Polyurethane biodegradation by Serratia sp. HY-72 isolated from the intestine of the Asian mantis Hierodula patellifera. Front. Microbiol. 2022, 13, 1005415. [Google Scholar] [CrossRef]
- Harder, W.; Dijkhuizen, L. Physiological responses to nutrient limitation. Annu. Rev. Microbiol. 1983, 37, 1–23. [Google Scholar] [CrossRef]
- Allison, S.D.; Vitousek, P.M. Responses of extracellular enzymes to simple and complex nutrient inputs. Soil Biol. Biochem. 2005, 37, 937–944. [Google Scholar] [CrossRef]
- Görke, B.; Stülke, J. Carbon catabolite repression in bacteria: Many ways to make the most out of nutrients. Nat. Rev. Microbiol. 2008, 6, 613–624. [Google Scholar] [CrossRef]
- Denaro, R.; Aulenta, F.; Crisafi, F.; Di Pippo, F.; Viggi, C.C.; Matturro, B.; Tomei, P.; Smedile, F.; Martinelli, A.; Di Lisio, V.; et al. Marine hydrocarbon-degrading bacteria breakdown poly (ethylene terephthalate) (PET). Sci. Total Environ. 2020, 749, 141608. [Google Scholar] [CrossRef]
- Kumari, A.; Bano, N.; Bag, S.K.; Chaudhary, D.R.; Jha, B. Transcriptome-guided insights into plastic degradation by the marine bacterium. Front. Microbiol. 2021, 12, 751571. [Google Scholar] [CrossRef]
- Yan, F.; Wei, R.; Cui, Q.; Bornscheuer, U.T.; Liu, Y.J. Thermophilic whole-cell degradation of polyethylene terephthalate using engineered Clostridium thermocellum. Microb. Biotechnol. 2021, 14, 374–385. [Google Scholar] [CrossRef]
- Joo, S.; Cho, I.J.; Seo, H.; Son, H.F.; Sagong, H.Y.; Shin, T.J.; Choi, S.Y.; Lee, S.Y.; Kim, K.J. Structural insight into molecular mechanism of poly (ethylene terephthalate) degradation. Nat. Commun. 2018, 9, 382. [Google Scholar] [CrossRef]
- Danso, D.; Chow, J.; Streit, W.R. Plastics: Environmental and biotechnological perspectives on microbial degradation. Appl. Environ. Microbiol. 2019, 85, e01095-19. [Google Scholar] [CrossRef]
- Gercke, D.; Furtmann, C.; Tozakidis, I.E.; Jose, J. Highly crystalline post-consumer PET waste hydrolysis by surface displayed PETase using a bacterial whole-cell biocatalyst. ChemCatChem 2021, 13, 3479–3489. [Google Scholar] [CrossRef]

Disclaimer/Publisher’s Note: The statements, opinions and data contained in all publications are solely those of the individual author(s) and contributor(s) and not of MDPI and/or the editor(s). MDPI and/or the editor(s) disclaim responsibility for any injury to people or property resulting from any ideas, methods, instructions or products referred to in the content. |
© 2023 by the authors. Licensee MDPI, Basel, Switzerland. This article is an open access article distributed under the terms and conditions of the Creative Commons Attribution (CC BY) license (https://creativecommons.org/licenses/by/4.0/).
Share and Cite
Kim, J.-H.; Lee, S.-H.; Lee, B.-M.; Son, K.-H.; Park, H.-Y. Biodegradation Potential of Polyethylene Terephthalate by the Two Insect Gut Symbionts Xanthomonas sp. HY-74 and Bacillus sp. HY-75. Polymers 2023, 15, 3546. https://doi.org/10.3390/polym15173546
Kim J-H, Lee S-H, Lee B-M, Son K-H, Park H-Y. Biodegradation Potential of Polyethylene Terephthalate by the Two Insect Gut Symbionts Xanthomonas sp. HY-74 and Bacillus sp. HY-75. Polymers. 2023; 15(17):3546. https://doi.org/10.3390/polym15173546
Chicago/Turabian StyleKim, Jong-Hoon, So-Hye Lee, Byeong-Min Lee, Kwang-Hee Son, and Ho-Yong Park. 2023. "Biodegradation Potential of Polyethylene Terephthalate by the Two Insect Gut Symbionts Xanthomonas sp. HY-74 and Bacillus sp. HY-75" Polymers 15, no. 17: 3546. https://doi.org/10.3390/polym15173546
APA StyleKim, J.-H., Lee, S.-H., Lee, B.-M., Son, K.-H., & Park, H.-Y. (2023). Biodegradation Potential of Polyethylene Terephthalate by the Two Insect Gut Symbionts Xanthomonas sp. HY-74 and Bacillus sp. HY-75. Polymers, 15(17), 3546. https://doi.org/10.3390/polym15173546

